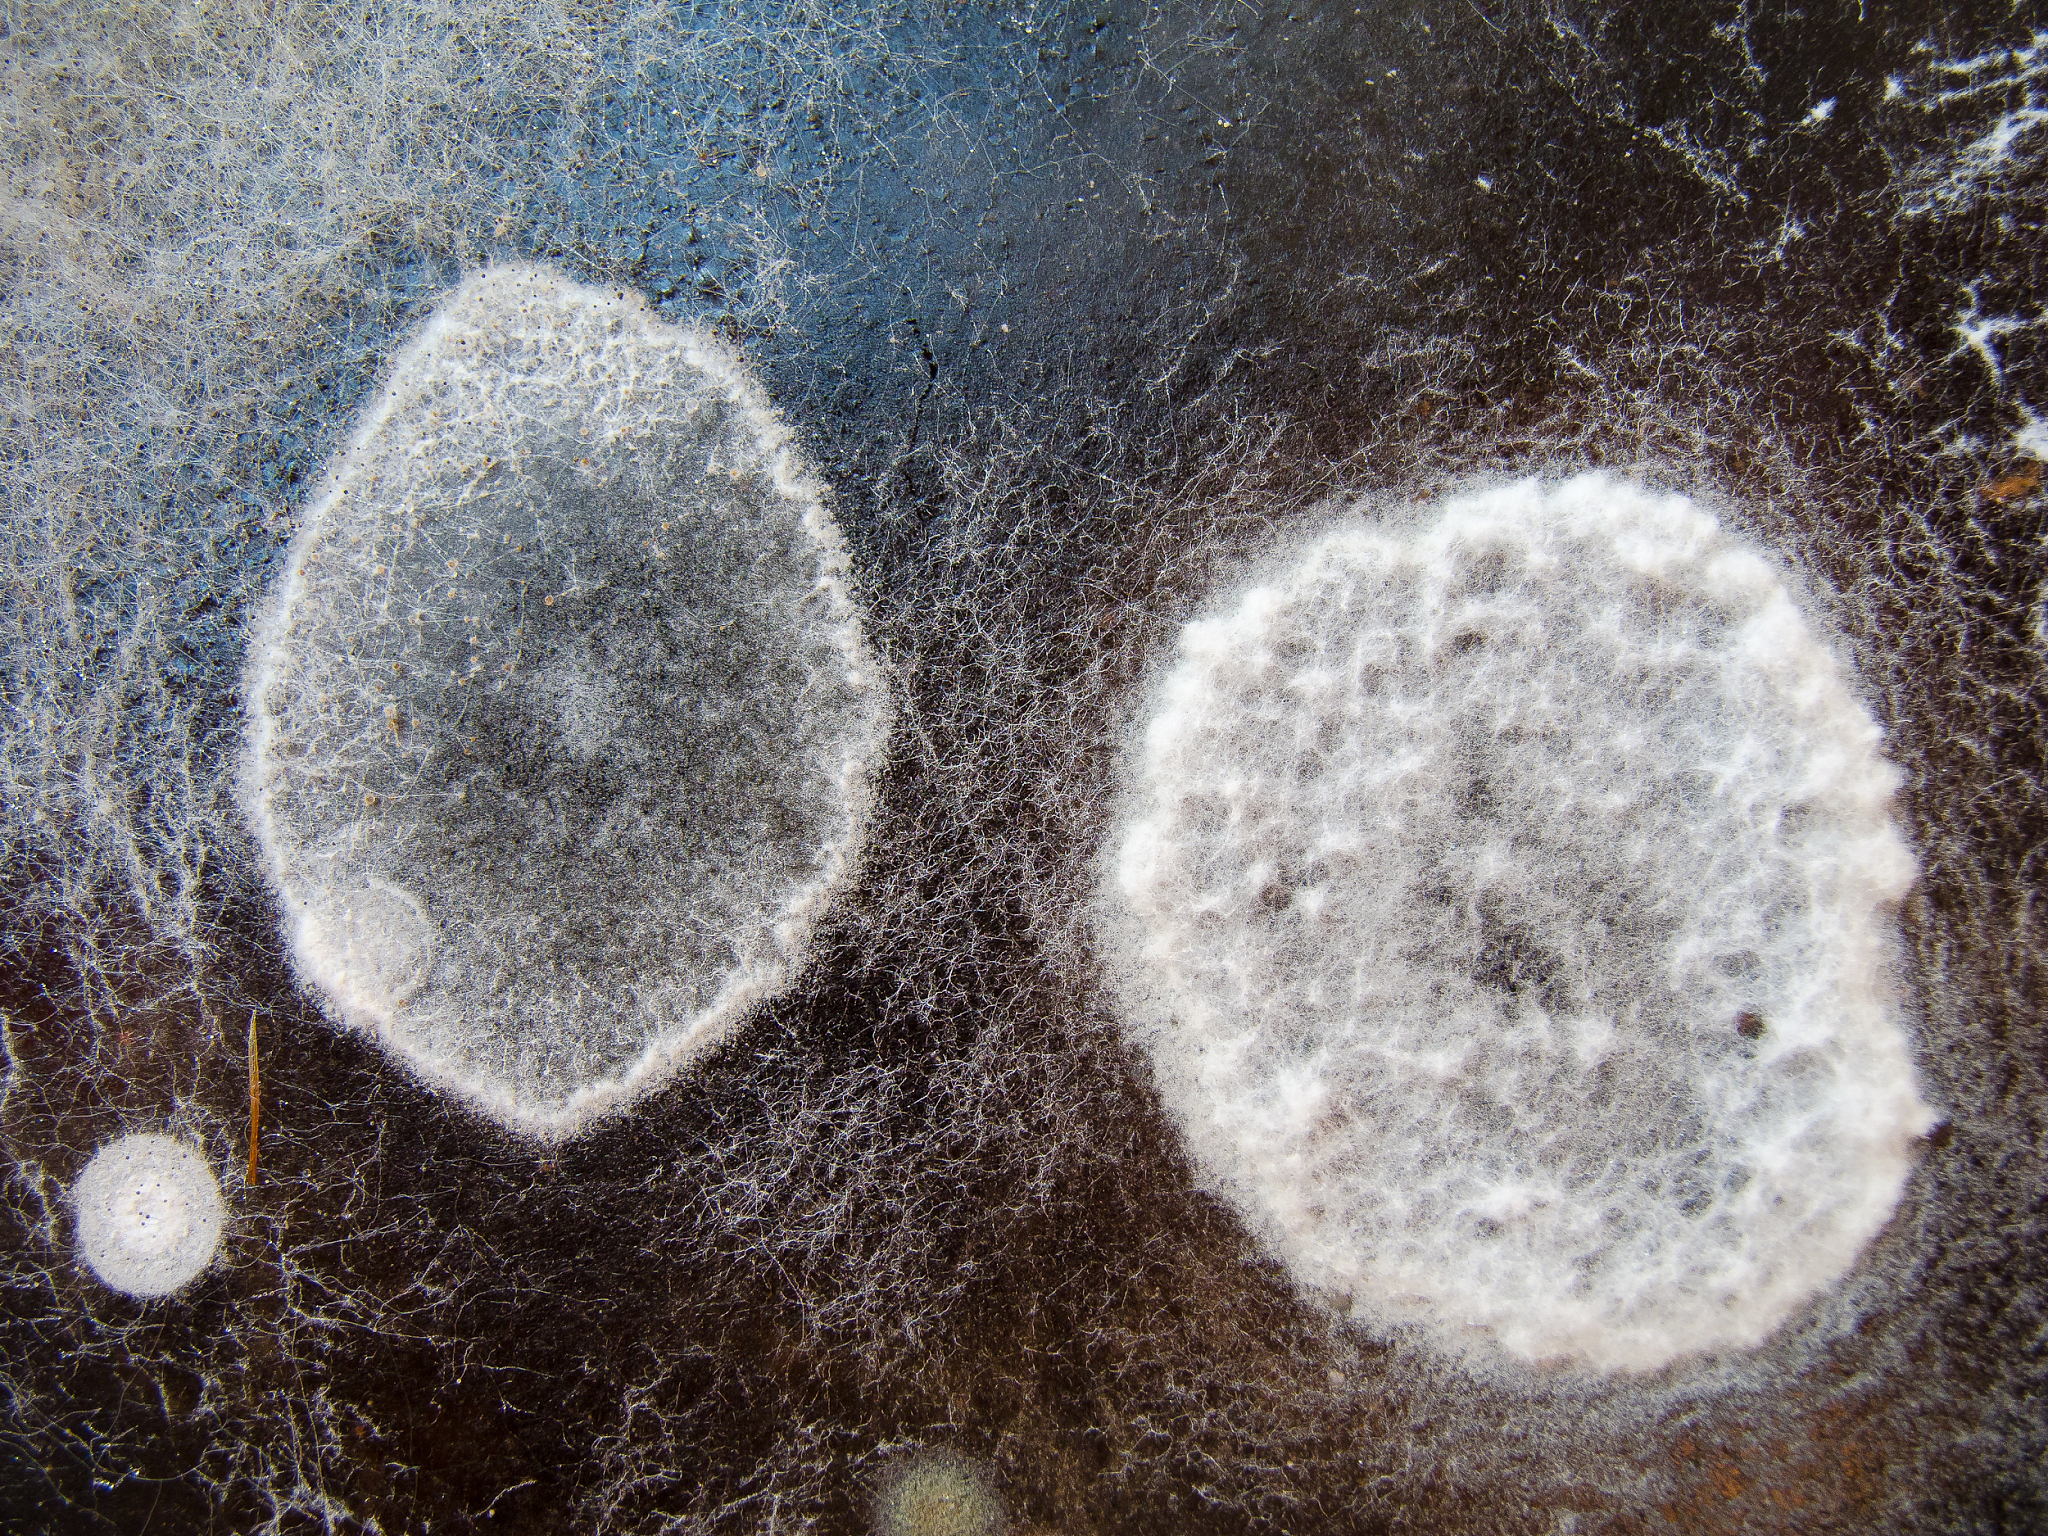
热杀索丝菌Brochothrix thermosphacta

热杀索丝菌Brochothrix thermosphacta
热杀索丝菌(Brochothrix thermosphacta)是一种革兰氏阳性细菌,属于芽孢杆菌目(Bacillales),热杀索丝菌主要存在于肉类和家禽等食品中。它是一种产生异味和腐败的细菌,可以在冷藏和冷冻温度下存活并繁殖,因此常常是肉类和家禽食品变质的原因之一。热杀索丝菌可以通过加热和消毒来杀灭,因此在食品加工和存储过程中需要注意卫生和温度控制。
原文地址: https://www.cveoy.top/t/topic/bZGg 著作权归作者所有。请勿转载和采集!